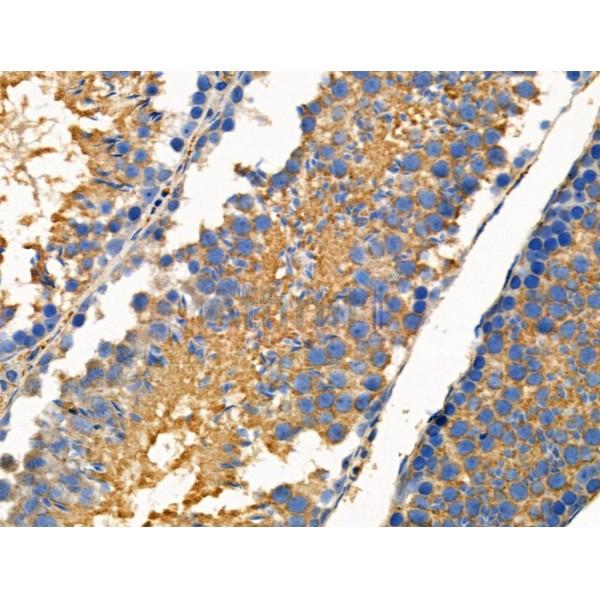
Phospho-FGF23 (Ser212) Antibody - AF3542 at 1/100 staining Mouse testis tissue by IHC-P.

Phospho-FGF23 (Ser212) Antibody - #AF3542
| Product: | Phospho-FGF23 (Ser212) Antibody |
| Catalog: | AF3542 |
| Description: | Rabbit polyclonal antibody to Phospho-FGF23 (Ser212) |
| Application: | IHC |
| Reactivity: | Human, Mouse, Rat |
| Mol.Wt.: | 30kD; 28kD(Calculated). |
| Uniprot: | Q9GZV9 |
| RRID: | AB_2846856 |
Product Info
*The optimal dilutions should be determined by the end user. For optimal experimental results, antibody reuse is not recommended.
*Tips:
WB: For western blot detection of denatured protein samples. IHC: For immunohistochemical detection of paraffin sections (IHC-p) or frozen sections (IHC-f) of tissue samples. IF/ICC: For immunofluorescence detection of cell samples. ELISA(peptide): For ELISA detection of antigenic peptide.
Cite Format: Affinity Biosciences Cat# AF3542, RRID:AB_2846856.
Fold/Unfold
ADHR; FGF-23; Fgf23; FGF23_HUMAN; FGFN; Fibroblast growth factor 23; Fibroblast growth factor 23 C-terminal peptide; Fibroblast growth factor 23 precursor; HPDR2; HYPF; Phosphatonin; PHPTC; Tumor derived hypophosphatemia inducing factor; Tumor-derived hypophosphatemia-inducing factor;
Immunogens
A synthesized peptide derived from human FGF23 around the phosphorylation site of Ser212.
Expressed in osteogenic cells particularly during phases of active bone remodeling. In adult trabecular bone, expressed in osteocytes and flattened bone-lining cells (inactive osteoblasts).
- Q9GZV9 FGF23_HUMAN:
- Protein BLAST With
- NCBI/
- ExPASy/
- Uniprot
MLGARLRLWVCALCSVCSMSVLRAYPNASPLLGSSWGGLIHLYTATARNSYHLQIHKNGHVDGAPHQTIYSALMIRSEDAGFVVITGVMSRRYLCMDFRGNIFGSHYFDPENCRFQHQTLENGYDVYHSPQYHFLVSLGRAKRAFLPGMNPPPYSQFLSRRNEIPLIHFNTPIPRRHTRSAEDDSERDPLNVLKPRARMTPAPASCSQELPSAEDNSPMASDPLGVVRGGRVNTHAGGTGPEGCRPFAKFI
Research Backgrounds
Regulator of phosphate homeostasis. Inhibits renal tubular phosphate transport by reducing SLC34A1 levels. Upregulates EGR1 expression in the presence of KL (By similarity). Acts directly on the parathyroid to decrease PTH secretion (By similarity). Regulator of vitamin-D metabolism. Negatively regulates osteoblast differentiation and matrix mineralization.
Following secretion this protein is inactivated by cleavage into a N-terminal fragment and a C-terminal fragment. The processing is effected by proprotein convertases.
O-glycosylated by GALT3. Glycosylation is necessary for secretion; it blocks processing by proprotein convertases when the O-glycan is alpha 2,6-sialylated. Competition between proprotein convertase cleavage and block of cleavage by O-glycosylation determines the level of secreted active FGF23.
Secreted.
Note: Secretion is dependent on O-glycosylation.
Expressed in osteogenic cells particularly during phases of active bone remodeling. In adult trabecular bone, expressed in osteocytes and flattened bone-lining cells (inactive osteoblasts).
Belongs to the heparin-binding growth factors family.
Research Fields
· Cellular Processes > Cell motility > Regulation of actin cytoskeleton. (View pathway)
· Environmental Information Processing > Signal transduction > MAPK signaling pathway. (View pathway)
· Environmental Information Processing > Signal transduction > Ras signaling pathway. (View pathway)
· Environmental Information Processing > Signal transduction > Rap1 signaling pathway. (View pathway)
· Environmental Information Processing > Signal transduction > PI3K-Akt signaling pathway. (View pathway)
· Human Diseases > Cancers: Overview > Pathways in cancer. (View pathway)
· Human Diseases > Cancers: Specific types > Melanoma. (View pathway)
· Human Diseases > Cancers: Specific types > Breast cancer. (View pathway)
· Human Diseases > Cancers: Specific types > Gastric cancer. (View pathway)
Restrictive clause
Affinity Biosciences tests all products strictly. Citations are provided as a resource for additional applications that have not been validated by Affinity Biosciences. Please choose the appropriate format for each application and consult Materials and Methods sections for additional details about the use of any product in these publications.
For Research Use Only.
Not for use in diagnostic or therapeutic procedures. Not for resale. Not for distribution without written consent. Affinity Biosciences will not be held responsible for patent infringement or other violations that may occur with the use of our products. Affinity Biosciences, Affinity Biosciences Logo and all other trademarks are the property of Affinity Biosciences LTD.